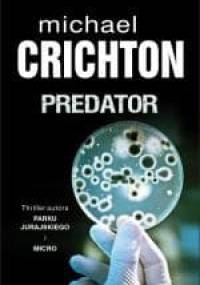
Predator - Michael Crichton

Elementy metodologii filozofii - Józef Herbut
- Dodał: administrator
- Data: 22:22 12-11-2018
- Kategoria: Filozofia i etyka

PHP 7. Algorytmy i struktury danych - Rahman Mizanur
- Dodał: administrator
- Data: 02:56 11-11-2018
- Kategoria: Informatyka i matematyka

Niepełnosprawność w kontekstach kulturowych i teoretycznych - Beata Borowska-Beszta
- Dodał: administrator
- Data: 15:55 10-11-2018
- Kategoria: Literatura popularnonaukowa

Teoria kwantów. Mechanika falowa - Iwo Białynicki-Birula
- Dodał: administrator
- Data: 13:42 10-11-2018
- Kategoria: Nauki przyrodnicze (fizyka, chemia, biologia, itd.)

Gramatyka opisowa klasycznej łaciny w ujęciu strukturalnym - Hubert Wolanin
- Dodał: administrator
- Data: 06:51 10-11-2018
- Kategoria: Językoznawstwo, nauka o literaturze

SQL. Jak osiągnąć mistrzostwo w konstruowaniu zapytań - Katarzyna Żmuda
- Dodał: administrator
- Data: 21:01 09-11-2018
- Kategoria: Informatyka i matematyka

Predator - Michael Crichton
- Dodał: administrator
- Data: 21:37 07-11-2018
- Kategoria: Thriller/sensacja/kryminał

Kuchnia kresowa - Małgorzata Caprari
- Dodał: administrator
- Data: 22:42 06-11-2018
- Kategoria: Kulinaria, przepisy kulinarne

Podstawy rysunku architektonicznego i krajobrazowego
- Dodał: administrator
- Data: 17:49 06-11-2018
- Kategoria: Sztuka

Przewodnik z Tybetu. Na ścieżce przeznaczenia - Ben Poll
- Dodał: administrator
- Data: 17:23 06-11-2018
- Kategoria: Thriller/sensacja/kryminał